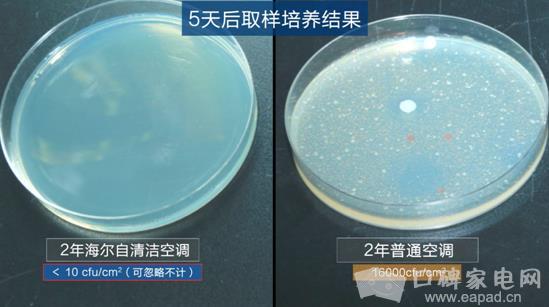

海尔智能自清洁空调吹白毛巾背后的三个报告
近日,一组海尔智能自清洁空调吹白毛巾洁净如新的视频引发200多万网友参与讨论。4月17日,中科院给出了三个实验报告,解释了海尔智能自清洁空调吹白毛巾背后的真相:依托原创自清洁技术,海尔智能自清洁空调不会滋生细菌,而且蒸发器本身具有抗菌性,能有效减少空气中的细菌,杜绝室内空气二次污染。

中科院报告从微观角度展示了海尔智能自清洁空调和普通空调蒸发器表面细菌滋生情况,背后反映的是现阶段用户对洁净空气的需求。普通空调蒸发器细菌滋生严重,威胁用户健康已成为常态。在空调日常运行中,随出风会向外界传播大量细菌,人体吸入可能引发呼吸系统疾病,甚至增加患其他疾病的风险。
而海尔抓住这一用户痛点,原创出吹白毛巾始终洁净、不滋生细菌的智能自清洁空调。依托行业首创的专利自清洁技术,利用水结霜产生的强大冷膨胀力,能够强力剥离污垢,保持空调内部洁净。同时蒸发器应用银离子抗菌涂层,抑菌率高达99.9%,铲除了细菌滋生的温床。
事实上,智能自清洁空调解决用户洁净空调需求,背后反映的是海尔智能制造满足用户需求的转型升级,以及践行国家供给侧结构性改革的实践。海尔智能制造的本质就是大规模定制,最终实现高精度抓取用户需求,并在海尔互联工厂端整合一流资源将需求变成大规模的定制订单。
目前,依托海尔COSMOPlat大规模定制的平台,用户可以全流程参与产品设计研发、生产制造、物流配送、迭代升级等环节,用户可以提出自己的创意,并与所有其他用户以及设计资源进行交互,共同完成设计创意。最终实现用户“既是消费者也是设计者、生产者"”的多种职能,形成了用户驱动的商业模式。
海尔在青岛西海岸新区、胶州、郑州建立的3座全球最领先空调互联工厂,能够通过大规模定制高精度高效率满足用户需求。数据显示,上市2年来,因满足了用户对洁净空气的需求,海尔智能自清洁空调销量已超400万套,成为现象级空调产品。凭借智能自清洁等原创智能产品,海尔连续38个月稳居国内智能空调第一。
